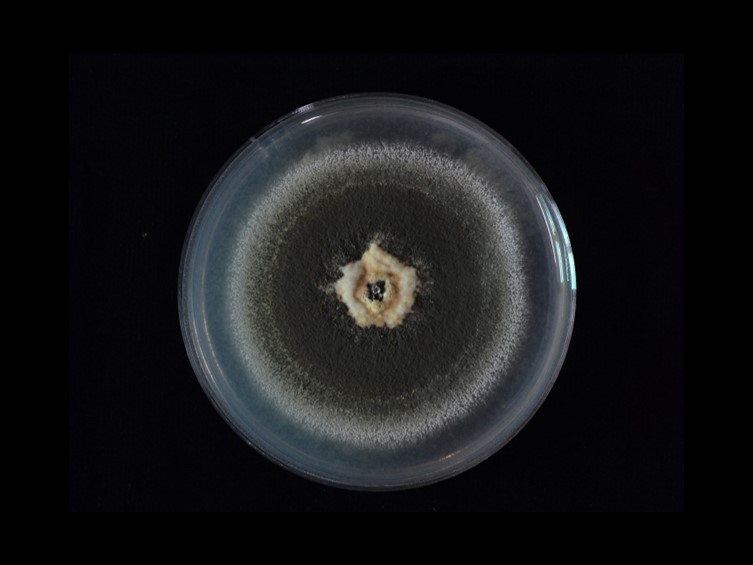

Holotype:
THAILAND, Nakhon Ratchasima, Khao Yai National Park, 16 Aug. 2009, K. Tasanathai, P. Srikitikulchai, S. Mongkolsamrit, T. Chohmee, R. Ridkaew, holotype BBH 26560, ex-type living culture BCC 37941.
Habitat:
Leaf litter, soil.
Host:
On wasp (Hymenoptera).
Culture characteristics:
Colonies on PDA medium attaining a diam of 40–42 mm in 14 d, dark green, flat, entire edge, border white, dark green of colonies due to production of
Colonies on PDA medium attaining a diam of 40–42 mm in 14 d, dark green, flat, entire edge, border white, dark green of colonies due to production of  conidia, pale yellow in the middle of the colony. Sporulation starting 5 d after inoculation, reverse pale yellow, orange in the middle of the colony. Conidiophores terminating in branches with 2–3
conidia, pale yellow in the middle of the colony. Sporulation starting 5 d after inoculation, reverse pale yellow, orange in the middle of the colony. Conidiophores terminating in branches with 2–3  phialides per branch. Phialides cylindrical with semi-papillate apices, 5–12 × 1.5–3 μm. Conidia smooth-walled, cylindrical with round apices, 7–10 × 2–3 μm.
phialides per branch. Phialides cylindrical with semi-papillate apices, 5–12 × 1.5–3 μm. Conidia smooth-walled, cylindrical with round apices, 7–10 × 2–3 μm.
Reference:
Kobmoo N, Mongkolsamrit S, Khonsanit K, et al. (2024). Integrative taxonomy of Metarhizium anisopliae species complex, based on phylogenomics combined with morphometrics, metabolomics, and virulence data. IMA Fungus13: 30.
DOI: https://doi.org/10.1186/s43008-024-00154-9Species |
Strain |
Compound |
Pubchem CID |
Biological activity |
Reference |
|---|
|
Strain |
|---|